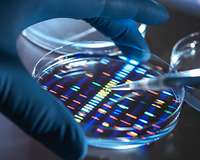
Eine Hand tropft aus einer Pipette auf eine Petrischale

© Ipopba/iStock/Getty Images Plus
Daten sind für immer mehr Unternehmen ein wichtiger Inputfaktor. Damit die Datenökonomie dem Gemeinwohl dienen kann und ihre Wertschöpfungspotenziale voll ausgenutzt werden können, gibt es eine Reihe von politischen Bestrebungen die Datenwirtschaft zu gestalten. Im Folgenden erklärt die DIHK die wichtigsten Begriffe, die in der Datenökonomie aktuell diskutiert werden.